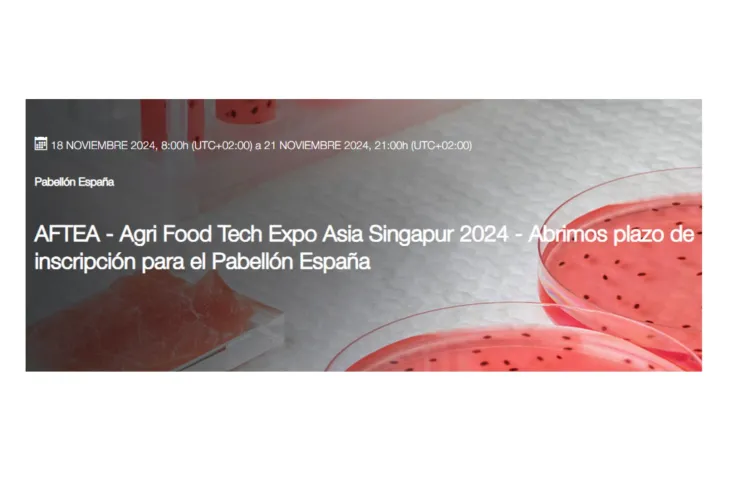
Banner del plataforma Agri Food Tech Expo Asia 2024

Buscar
Sumario de resultados
TIpos de contenido
Fecha
-
-
 Convocatoria
ConvocatoriaIniciativa TransMisiones 2024
-
 Noticia
NoticiaLa American Association for Cancer Research (AACR) nombra a Manuel Hidalgo miembro de su j...
El Dr. Manuel Hidalgo trabaja junto a Peaches Biotech en el desarrollo de un nuevo tratamiento denominado opT cells, nacido de un proyecto de colaboración con la Harvard Medical School.
-
 Noticia
NoticiaEstudios preclínicos validan el potencial de ApTOLL para reducir la inflamación y regenera...
ApTOLL ha dado muestras de su potencial para frenar la progresión de la esclerosis múltiple (EM) en estudios preclínicos con animales.
-
 Noticia
NoticiaAMSbiopharma presenta un importante avance con el análisis de nitrosaminas en principios f...
Las nitrosaminas representan un riesgo significativo para la salud, siendo potencialmente carcinogénicas y de origen preocupante en los procesos de fabricación farmacéutica
-
Evento
EventoAgri Food Tech Expo Asia 2024
Una jornada organizada para presentar las soluciones foodtech más disruptivas del Sudeste Asiático. La Convocatoria Pabellón España de ICEX, abierta hasta el 28 de junio
-
 Empresa
EmpresaBATEA ONCOLOGY S.L.
-
 Noticia
Noticia#NuevoSocioAseBio | “Esta asociación nos brinda la posibilidad de establecer contactos cla...
Conoce a Kirsch Pharma, nuestro nuevo socio. Hablamos con Raquel Márquez Duro, Key Account Mánager de España y Portugal.
-
 Noticia
NoticiaLa biotecnología revoluciona los avances frente a la obesidad: mayor conocimiento, diagnó...
Con el objetivo de abordar cómo la biotecnología está posibilitando avances frente a la obesidad desde diferentes enfoques y, en el marco de celebración del Día Europeo contra la Obesidad
-
 Evento
EventoEncuentro construyendo sinergias
La Junta de Castilla y León, junto al Instituto de Ciencias de la Salud de Castilla y León, organiza el encuentro 'Construyendo sinergias', una jornada de investigación e innovación en salud que se
-
 Oferta de empleo
Oferta de empleoSoftware Developer
-
 Noticia
NoticiaBiotecnología Sanitaria - Boletín primer trimestre 2024
Este boletín de Vigilancia Tecnológica en Biotecnología aplicada al sector sanitario surge del trabajo conjunto entre la Oficina Española de Patentes y Marcas (OEPM), AseBio y la Plataforma de
-
 Noticia
Noticia#GaleríaAseBio | Así fue el AseBio Investor Day 2024
Este miércoles 15 de mayo, AseBio celebró la quinta edición del AseBio Investor Day, un evento que se erige como uno de los principales puntos de encuentro entre inversores nacionales e
-
 Noticia
NoticiaPolíticas regulatorias efectivas y flexibles, mayor inversión en I+D y sensibilización soc...
A nivel regulatorio y político, España cuenta con la Estrategia de Bioeconomía Integral desde el año 2015, pero apenas ha evolucionado con el tiempo y no ha logrado tener un impacto significativo.
-
 Nota de prensa
Nota de prensaPolíticas regulatorias efectivas y flexibles, mayor inversión en I+D y sensibilización soc...
En el marco de celebración del AseBio Investor Day 2024 varios expertos han analizado los retos y oportunidades del sector de la bioeconomía en España. Desde el año 2010, como parte de la Estrategia
-
 Noticia
NoticiaLas ‘biotech’ españolas captan 228 millones de euros de financiación privada en 2023
En el marco del AseBio Investor Day, AseBio ha adelantado los datos sobre financiación privada recogidos en el Informe AseBio 2023, que se presentará el próximo 12 de junio en la Fundación Rafael del
-
 Nota de prensa
Nota de prensaLas ‘biotech’ españolas captan 228 millones de euros de financiación privada en 2023
En el marco del AseBio Investor Day, celebrado este 15 de mayo en San Sebastián, AseBio ha adelantado los datos sobre financiación privada recogidos en el Informe AseBio 2023. El Informe AseBio 2023
-
 Oferta de empleo
Oferta de empleoResponsable NGS
-
 Noticia
NoticiaMikrobiomik inicia una ronda estratégica de inversión para impulsar su primer medicamento ...
La compañía biofarmacéutica vizcaína, que prevé lanzar su primer medicamento biológico al mercado en el primer semestre de 2025, destinará los fondos a ampliar su capacidad de producción y acelerar
-
 Oferta de empleo
Oferta de empleoTécnicos/as de Producción
-
 Oferta de empleo
Oferta de empleoTECNICO/A GMP

